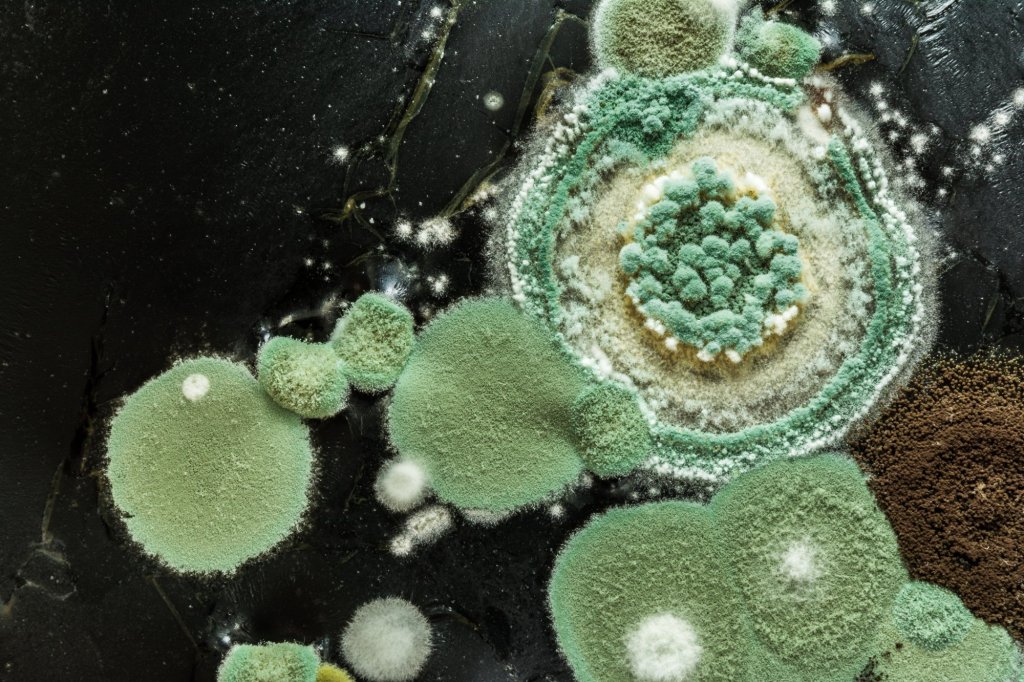

En la primera mitad del siglo XX la historia de los antibióticos comenzó con un descubrimiento accidental: la penicilina. Un hongo, Penicillium notatum, produjo una sustancia capaz de eliminar las bacterias sin dañar las células del cuerpo humano. Este hallazgo revolucionó totalmente la medicina y marcó el inicio de una nueva era, la de los antibióticos.
A partir de la penicilina se desarrollaron otros como la estreptomicina, la tetraciclina y el cloranfenicol, que salvaron millones de vidas al combatir de forma eficaz enfermedades como la tuberculosis, la neumonía o la sífilis. En la década de 1960 hicieron su aparición las cefalosporinas y los aminoglucósidos, ampliando aún más el arsenal terapéutico.
Sin embargo, el uso incontrolado de estos medicamentos ha generado un problema creciente: la resistencia antibiótica. Las bacterias, en su lucha por la supervivencia, desarrollaron mecanismos para resistir a su acción, convirtiéndolas en una de las principales amenazas para la salud pública de este siglo.

Un antibiótico generado por inteligencia artificial
Más de un millón de personas mueren todos los años a consecuencia de infecciones por bacterias multiresistentes a los antibióticos. Esta cifra alarmante nos enfrenta a una realidad pavorosa: la resistencia a los antibióticos se ha convertido en una de las mayores amenazas para la salud pública. Sin embargo, la esperanza parece surgir en el lejano horizonte. En el año 2023, un grupo de científicos -utilizando la inteligencia artificial- logró un avance significativo: el descubrimiento de un nuevo antibiótico capaz de combatir una de las superbacterias más mortales: la Acinetobacter baumannii.
Este nuevo antibiótico, llamado abaucina, ofrece una nueva esperanza. Sin embargo, aún queda un largo camino por recorrer, por lo que no debemos bajar la guardia y hacer un uso racional de los antibióticos.
Un hito español en la lucha contra las bacterias
En la historia de la lucha contra las bacterias, España ha jugado un papel fundamental. Un ejemplo notable es el descubrimiento de la fosfomicina, un antibiótico con una historia fascinante que nace de la pasión y dedicación de la microbióloga Sagrario Mochales.
En 1969, mientras trabajaba en el CSIC se embarcó en una búsqueda incansable de nuevos antibióticos. Su objetivo era explorar el potencial del suelo de la península Ibérica. Su tenacidad la llevó a un descubrimiento accidental: una cepa de Streptomyces fradiae con actividad antimicrobiana. El suceso tuvo lugar en la tierra de la carretera que une Jávea y Gata de Gorgos (Alicante).
Este descubrimiento marcó un hito en la historia de la medicina española al convertirse en un antibiótico de gran eficacia para combatir diversas infecciones.
África: un tesoro de potenciales antibióticos
La rica biodiversidad de África convierte a este continente en una fabulosa arca de Noé para el descubrimiento de nuevos antibióticos. Hasta la fecha se han encontrado varios antibióticos en el suelo de diferentes países africanos: actinomicina (Madagascar), daptomicina (Tanzania), neomicina (Uganda), rifampicina (República Democrática del Congo), teicoplanina (Nigeria) o vancomicina (Ghana). Estos descubrimientos son un verdadero tesoro para la comunidad científica y ofrecen un amplio abanico de posibilidades para combatir diferentes enfermedades infecciosas.
El antibiótico más vendido
La amoxicilina es el antibiótico más vendido hasta la fecha. Se trata de un medicamento eficaz y generalmente bien tolerado que se utiliza para tratar una amplia gama de infecciones bacterianas.
El antibiótico que salvó al hijo del descubridor
En el año 1943 se produjo el descubrimiento de la estreptomicina gracias al trabajo del científico Selman Waksman. Un antibiótico que fue elaborado a partir de una bacteria del suelo llamada Streptomyces griseus. La estreptomicina no solo significó un gran avance en la lucha contra las enfermedades bacterianas, sino que también tejió una historia personal realmente conmovedora.
La tuberculosis, una enfermedad que hasta entonces era mortal en la mayoría de los casos, encontró en la estreptomicina un temible competidor. La estreptomicina redujo significativamente la tasa de mortalidad por esa enfermedad y salvó millones de vidas en todo el mundo.
La historia personal de Waksman añade un toque aún más emotivo al descubrimiento y es que Boris, el hijo del científico, contrajo la tuberculosis en 1946. El teutón le administró la estreptomicina, que aún se encontraba en fase experimental, salvando la vida de su hijo.

Antibióticos en la Estación Espacial Internacional
La Estación Espacial Internacional (EEI), un laboratorio en órbita terrestre, representa un desafío único para la salud humana. Los astronautas están expuestos a condiciones extremas que pueden aumentar su susceptibilidad a las infecciones. Para proteger su salud, la EEI lleva a bordo una farmacia espacial con una amplia variedad de antibióticos.
Algunos de los fármacos que se han llevado a la EEI son: gentamicina, amikacina, amoxicilina, vancomicina, ciprofloxacino, levofloxacino, doxiciclina o metronidazol.
Referencias:
- Gargantilla Madera, P. Historia de la Medicina. Editorial Pinolia, 2023.
- Gargantilla Madera, P. Breve historia de la medicina. Editorial Nowtilus, 2011.